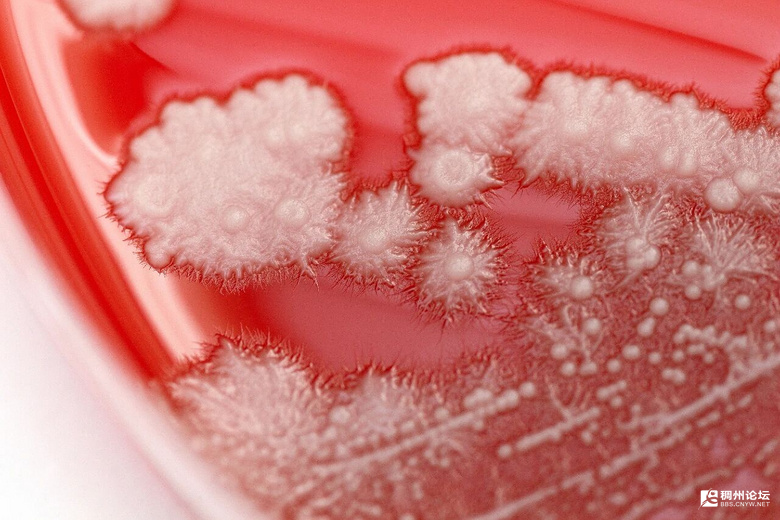

眼下正值秋冬换季时,也是呼吸道疾病的高发期,身边很多人都出现了感冒发烧或者喉咙痛。遇到这样的情况,不少网友都会自行吃点抗生素药物“消消炎”。
宁波36岁的张先生(化名)起初也是这么想的,谁知一顿操作后,病不但没好,反而“雪上加霜”。喉咙痛有一个多月了,药是吃了一堆,可就是不见好!
宁波市北仑区第二人民医院耳鼻喉科主任邬忠伟敏锐洞察到,这可能不是普通感冒那么简单,之后的喉镜检查也验证了判断。
通过检查,邬忠伟发现张先生的整个咽后壁有一层白茫茫的“雪花”,最终他被确诊为真菌性咽喉炎,罪魁祸首不是细菌,而是白色念珠菌。
平时是不是经常服用抗生素药物?”面对询问,张先生频频点头。
原来,从事销售工作的张先生每天都很忙,熬夜、出差都是常态,但凡遇上头疼脑热,他就到药店买点头孢或阿奇霉素吃。
“抗生素虽然能杀灭致病菌,但是它会不分青红皂白地把口腔里的‘好菌’和‘坏菌’一起杀光,白色念珠菌便会趁机疯长。”邬忠伟解释,而长时间的高压节奏也会导致身体免疫力下降,在多重因素影响下,最终引发了真菌性咽喉炎。
之后,邬忠伟让张先生立即停用抗生素,并为其开具抗真菌药。所幸,经一段时间的相应治疗,目前张先生咽部的“雪花”已基本消退,疼痛也有明显缓解。
张先生的故事并非个例。邬忠伟表示,不少真菌性咽喉炎患者就诊前都会自行服药。
在医院门诊遇到的真菌性咽喉炎患者中,有近八成都有自行服用抗生素史,更有糖尿病患者把咽痛当“上火”,胡乱吃药结果引发真菌性肺炎的,这种情况在换季时尤为多见。
邬忠伟强调,抗生素不是万能药,其对病毒、真菌、过敏等引起的炎症无效。70%的急性咽痛与病毒感染有关,血常规、C反应蛋白检测是判断细菌感染的重要指标,只有明确病因后才会考虑使用抗生素。
医生提醒,若出现咽痛、发热等情况,请及时就诊,尤其是糖尿病患者及免疫低下人群更要引起重视。
之后,邬忠伟让张先生立即停用抗生素,并为其开具抗真菌药。所幸,经一段时间的相应治疗,目前张先生咽部的“雪花”已基本消退,疼痛也有明显缓解。
张先生的故事并非个例。邬忠伟表示,不少真菌性咽喉炎患者就诊前都会自行服药。
在医院门诊遇到的真菌性咽喉炎患者中,有近八成都有自行服用抗生素史,更有糖尿病患者把咽痛当“上火”,胡乱吃药结果引发真菌性肺炎的,这种情况在换季时尤为多见。
邬忠伟强调,抗生素不是万能药,其对病毒、真菌、过敏等引起的炎症无效。70%的急性咽痛与病毒感染有关,血常规、C反应蛋白检测是判断细菌感染的重要指标,只有明确病因后才会考虑使用抗生素。
医生提醒,若出现咽痛、发热等情况,请及时就诊,尤其是糖尿病患者及免疫低下人群更要引起重视。
来源:新闻坊综合潮新闻